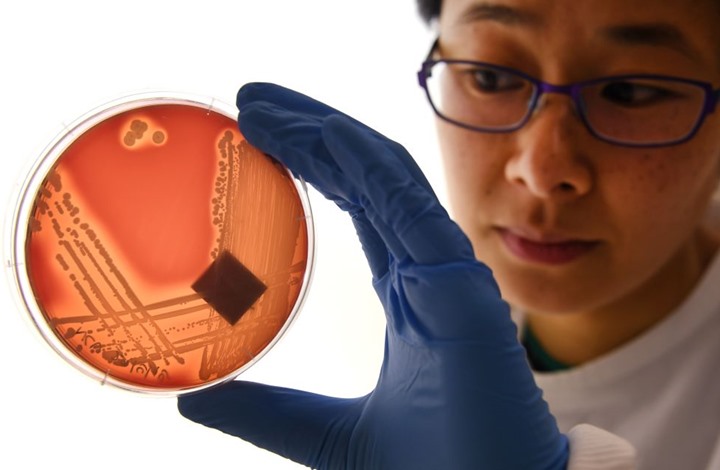

اكتشاف طريقة جديدة لتحويل الخلايا السرطانية الى مضادات فعّالة
اكتشف علماء، طريقة جديدة لتحويل الخلايا السرطانية إلى عوامل فعالة مضادة للسرطان، وفي أحدث عمل من مختبر الدكتور خالد شاه في مستشفى بريجهام والنساء، وهو عضو مؤسس لنظام الرعاية الصحية الشامل، طور الباحثون نهجًا جديدًا للعلاج بالخلايا للقضاء على الأورام المستقرة والحث على فترة طويلة مناعة المدى، وتدريب الجهاز المناعي للوقاية من تكرار الإصابة بالسرطان.
واختبر الفريق لقاحهم ثنائي المفعول والقاتل للسرطان في نموذج متقدم للفأر لسرطان الدماغ القاتل لسرطان أرومي دبقي، وحقق نتائج واعدة، وتم نشر النتائج في Science Translational Medicine.
وقال المؤلف خالد شاه مدير مركز الخلايا الجذعية والعلاج المناعي الانتقالي: “اتبع فريقنا فكرة بسيطة وهي أخذ الخلايا السرطانية وتحويلها إلى قاتلة ولقاحات للسرطان، باستخدام هندسة الجينات، ونقوم بإعادة توظيف الخلايا السرطانية لتطوير علاج يقتل الخلايا السرطانية ويحفز جهاز المناعة على حد سواء لتدمير الأورام الأولية والوقاية من السرطان.
وتعد لقاحات السرطان مجالًا نشطًا للبحث للعديد من المختبرات، لكن النهج الذي اتخذه شاه وزملاؤه متميز، فبدلاً من استخدام الخلايا السرطانية المعطلة، أعاد الفريق استخدام الخلايا السرطانية الحية، والتي تمتلك ميزة غير عادية، فتنتقل الخلايا السرطانية الحية لمسافات طوال عبر الدماغ، لتعود إلى موقع الخلايا السرطانية الأخرى، وبالاستفادة من هذه الخاصية الفريدة، صمم فريق شاه خلايا الورم الحية باستخدام أداة تحرير الجينات CRISPR-Cas9 وأعادوا توجيهها لإطلاق عامل قتل الخلايا السرطانية، وبالإضافة إلى ذلك، تم تصميم الخلايا السرطانية المهندسة للتعبير عن العوامل التي من شأنها أن تجعل من السهل على الجهاز المناعي اكتشافها ووسمها وتذكرها، مما يهيئ الجهاز المناعي لاستجابة طويلة الأمد لمكافحة الورم.
واختبر الفريق، الخلايا السرطانية العلاجية المُحسَّنة بتقنية CRISPR والمعتمدة على الهندسة العكسية (ThTC) في سلالات الفئران المختلفة، بما في ذلك تلك التي تحمل خلايا نخاع العظام والكبد والغدة الصعترية المشتقة من البشر، مما يحاكي البيئة المناعية البشرية المكروية.
وقام فريق شاه أيضًا ببناء مفتاح أمان ثنائي الطبقات في الخلية السرطانية، والتي عند تنشيطها، تقضي على ThTCs إذا لزم الأمر. كان هذا العلاج الخلوي مزدوج الفعل آمنًا وقابلاً للتطبيق وفعالًا في هذه النماذج، مما يشير إلى خارطة طريق نحو العلاج. في حين أن هناك حاجة إلى مزيد من الاختبارات والتطوير، اختار فريق شاه هذا النموذج على وجه التحديد واستخدم الخلايا البشرية لتسهيل مسار ترجمة النتائج التي توصلوا إليها من أجل إعدادات المريض.



